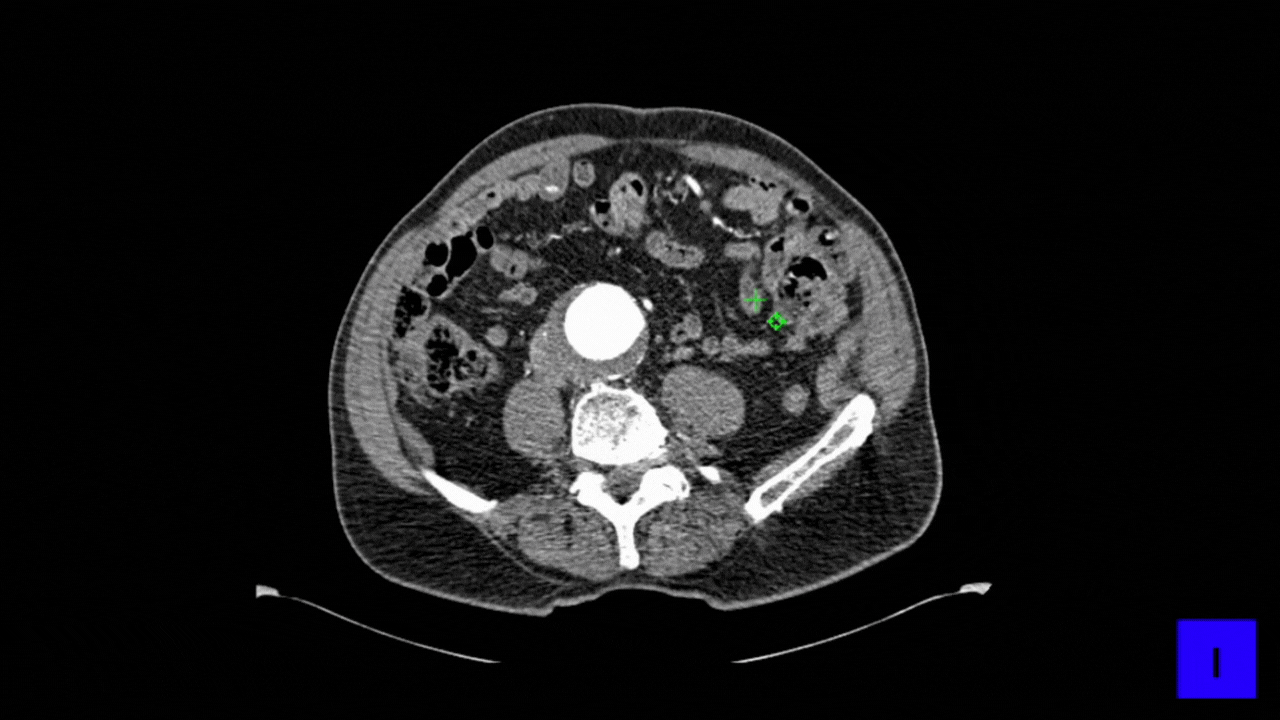

iSizing Auto
Introducing iSizing Auto! An automated aorta segmentation and sizing measurement software, powered by cutting-edge AI technology.
With age-old traditional methods, EVAR sizing procedures have been time-consuming and require expert-level proficiency to guarantee positive patient outcomes.
With iSizing Auto, physicians/clinical specialists can now access expert-level aorta sizing instantly through any digital device, streamlining their overall EVAR planning procedures.

Provides a standardized approach for EVAR planning.

Standard Measurement Method
AI-Companion for EVAR sizing procedure .

Time – Saving
Get aorta sizing measurements in just few clicks.

Receive direct measurements in a structured report, easy to read and share.
CE marked*
*PlanOp iSizing V1 is a medical device software (class IIa, CE 0123). As a manufacturer, PrediSurge provides more information with software output (Sizing report).
How it Works

CT Scan


iSizing Auto Platform


Sizing Report
Report Features
Proximal Neck Measurements
Measurements are done along Proximal neck each 0.5mm starting from baseline to distal end of the proximal neck.
Max and average diameters are computed, including lumen & thrombus, and if required, calcifications.


Max external diameter (including thrombus & calcifications).
Iliac Measurements
Measurements are performed every 0.5mm from origin to distal end of each common iliac artery.
Max and average diameters are computed, including lumen & thrombus, and if required, calcifications.

User Guide


Now, you can focus more on clinical decisions, not tedious measurements. Save your time by reducing manual workload.
Automated Segmentation and Sizing
iSizing Auto automatically segments the aorta and computes precise sizing measurements, streamlining the evaluation process.


Results: Download Sizing Report
Get key diameter and length measurements, along with related annotated images to support your EVAR planning.
Latest News
PrediSurge at SNITEM’s Innovative Start Up Day
Navigating the MedTech Frontier: Key Insights for Securing Growth leveraging insurance as a strategic tool.The health technology (MedTech) sector is a landscape of rapid innovation. Yet transforming groundbreaking ideas into long-term success calls for strategic risk...
Jean-Noel Albertini and Simona Zannetti / Full interview
This collaboration brings together Medtronic’s industry-leading Endurant™ stent graft with our AI-powered digital twin technology, empowering clinicians with advanced tools for risk assessment and aiming to enable more precise EVAR planning. Check out the press...
PlanOp 3DSim – When digital twin meets 3D Printed functional twin
An exciting collaboration between PrediSurge and 3Deus dynamicsAn ultra-realistic simulation tool for aortic interventions training and teaching PlanOp 3DSim Here below some shots of our recent demonstration where Pr. Feugier trained Dr Gleizes, a fellow, on...
Check out our new EVAR planning tool, iView Pro is now available in Europe with Meditronic’s Endurant.
For upcoming EVAR planning solutions of PrediSurge, check out our Social media.

iSizing Auto
With iSizing Auto, physicians/clinical specialists can now access expert-level aorta sizing instantly through any digital device, streamlining their overall EVAR planning procedures.

Streamline planning workflow
Provides a standardized approach for EVAR planning.

Standard Measurement Method
AI-Companion for EVAR sizing procedure.

Time – Saving
Get aorta sizing measurements in just few clicks.

Quick Access to results
Receive direct measurements in a structured report, easy to read and share.
CE marked*
*PlanOp iSizing V1 is a medical device software (class IIa, CE 0123). As a manufacturer, PrediSurge provides more information with software output (Sizing report).
How it works

CT Scan


iSizing Auto Platform


Sizing Report
Report Features

Measurements are done along Proximal neck each 0.5mm starting from baseline to distal end of the proximal neck.
Max and average diameters are computed, including lumen & thrombus, and if required, calcifications.

Aneurysm Measurements
Max external diameter (including thrombus & calcifications).

Iliac Measurements
Measurements are performed every 5mm from origin to distal end of each common iliac artery.
Max and average diameters are computed, including lumen & thrombus, and if required, calcifications.
User Guide

Upload your DICOM file containing the CT scan for automated measurements.
Now, you can focus more on clinical decisions, not tedious measurements. Save your time by reducing manual workload.

Automated Segmentation and Sizing
iSizing Auto automatically segments the aorta and computes precise sizing measurements, streamlining the evaluation process.

Results: Download Sizing Report
Get key diameter and length measurements, along with related annotated images to support your EVAR planning.
Latest News
PrediSurge at SNITEM’s Innovative Start Up Day
Navigating the MedTech Frontier: Key Insights for Securing Growth leveraging insurance as a strategic tool.The health technology (MedTech) sector is a landscape of rapid innovation. Yet transforming groundbreaking ideas into long-term success calls for strategic risk...
Jean-Noel Albertini and Simona Zannetti / Full interview
This collaboration brings together Medtronic’s industry-leading Endurant™ stent graft with our AI-powered digital twin technology, empowering clinicians with advanced tools for risk assessment and aiming to enable more precise EVAR planning. Check out the press...
PlanOp 3DSim – When digital twin meets 3D Printed functional twin
An exciting collaboration between PrediSurge and 3Deus dynamicsAn ultra-realistic simulation tool for aortic interventions training and teaching PlanOp 3DSim Here below some shots of our recent demonstration where Pr. Feugier trained Dr Gleizes, a fellow, on...
Check out our new EVAR planning tool, iView Pro is now available in Europe with Meditronic’s Endurant.
For upcoming EVAR planning solutions of PrediSurge, check out our Social media.